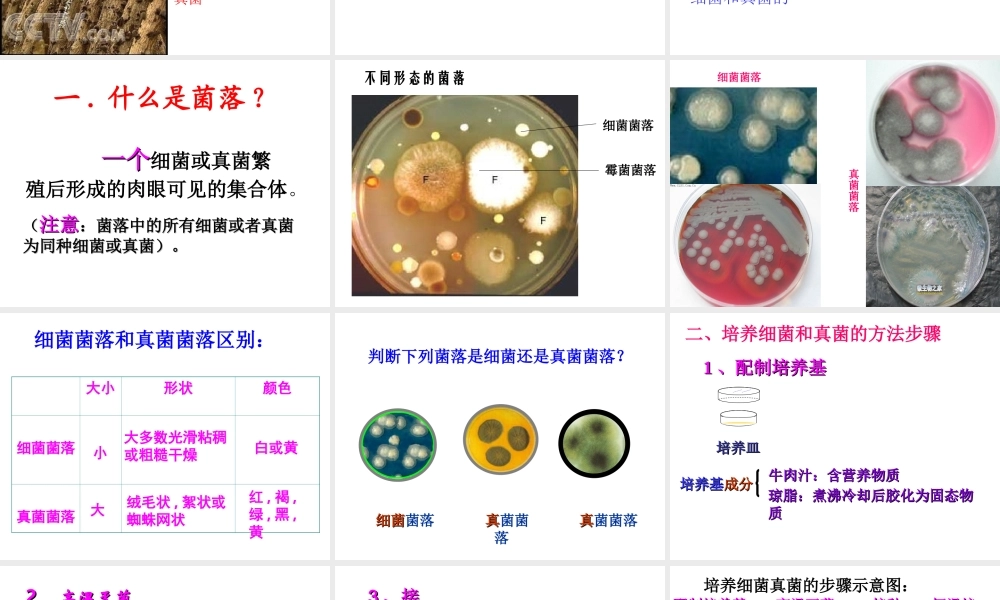
2014年秋八年级生物上册 第四章 第一节 细菌和真菌的分布课件 新人教版

第四章 分布广泛的细菌和真菌植物动物 馒头、水果存放久了为什么会长“毛”
这是真菌中的霉菌繁殖的结果腐烂的树枝上长出的蘑菇和木耳实际上是真菌腐烂的树枝怎么会长有蘑菇和木耳呢
你有没有见过细菌或真菌
在哪里看到的
第一节 细菌和真菌的分布1 、电子显微镜或高倍显微镜2 、我们是通过观察 来研究细菌和真菌的菌落一
一个一个细菌或真菌繁殖后形成的肉眼可见的集合体
((注意注意:菌落中的所有细菌或者真菌:菌落中的所有细菌或者真菌为同种细菌或真菌)
为同种细菌或真菌)
不同形态的菌落 细菌菌落霉菌菌落细菌菌落真菌菌落细菌菌落和真菌菌落区别:大小形状颜色细菌菌落 真菌菌落小大大多数光滑粘稠或粗糙干燥绒毛状 , 絮状或蜘蛛网状白或黄红 , 褐 ,绿 , 黑 ,黄细菌细菌菌落 真真菌菌落 真真菌菌落判断下列菌落是细菌还是真菌菌落
牛肉汁:含营养物质牛肉汁:含营养物质琼脂:煮沸冷却后胶化为固态物琼脂:煮沸冷却后胶化为固态物质质培养基培养基成分成分培养皿培养皿二、培养细菌和真菌的方法步骤11 、配制培养基、配制培养基22 、高温灭菌、高温灭菌 为什么培养用的培养皿和培养基,在实验前必须高温处理
因为经高温处理后,可以将培养皿上、培养基内混有的细菌和真菌的孢子杀死,这样就排除了实验外其他环境的污染
33 、接、接种种 细菌接种细菌接种,就是把已有的目标菌种,用某种方式取少量的菌种,转移到事先配好的培养基上
使其繁殖增长的一种活动
接种的目的就是获得更多的目标菌,或者筛选出自己想要的菌 44 、恒温培养、恒温培养培养皿要在恒温箱中或温暖的室内进行培养培养皿培养皿配制好的培养基配制好的培养基冷却冷却胶化胶化琼 脂琼 脂牛肉汁牛肉汁恒恒温温箱箱观察菌落观察菌落接种接种高温灭菌高温灭菌恒温培养恒温培养培养细菌真菌的步骤示意图:高温高压高温高压 灭菌